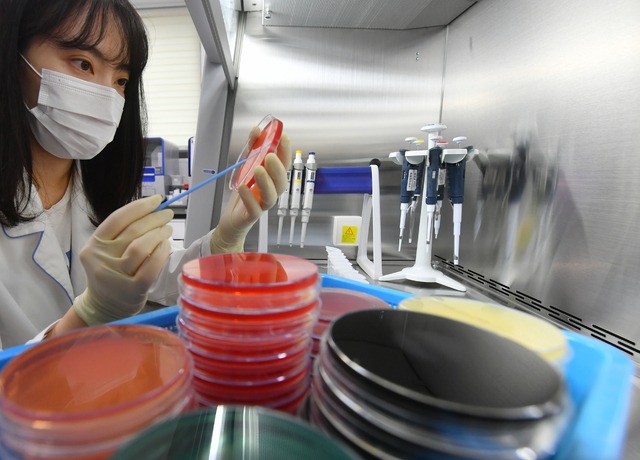

"기온 높아지는 여름철엔 세균성 식중독 발생 위험" 정부가 어린이 식중독 예방을 위해 유치원과 어린이집에서 운영하는 급식소 위생 점검에 나선다.
식품의약품안전처와 교육부, 보건복지부는 7월 한 달 동안 유치원 8000여 곳, 어린이집 3만5000여 곳을 대상으로 식재료 위생 관리 등을 점검한다고 3일 밝혔다.
최근 경기 안산의 한 유치원에서 집단 식중독이 발생한 데다 기온도 점차 상승하고 있어 식중독 예방 관리에 나선 것이다.
급식인원 50인 이상인 유치원 4000여 곳과 어린이집 1만2000여 곳은 식약처 주관으로 17개 지방자치단체 위생부서가 보존식을 보관하고 있는지, 위생 기준을 준수하고 있는지 여부를 점검한다.
급식인원 50인 미만인 곳 중 유치원 4000여 곳은 교육부 주관으로 시·도교육청이, 어린이집 2만3000여 곳은 복지부 주관으로 지자체 보육부서가 점검한다. 현장에서는 개인위생과 시설·설비, 식재료 관리에 중점을 두고 살필 예정이다.
정부는 소규모 시설에 대해 어린이급식관리지원센터 영양사와 함께 점검반을 구성해 식중독 예방 교육을 실시하고, 센터에 등록되지 않은 시설은 등록할 수 있도록 적극적으로 지원한다는 계획이다.
식약처와 교육부, 복지부는 태스크포스(TF)를 구성해 점검 결과를 분석하고 급식 위생 개선 대책을 마련하기로 했다.
정부 관계자는 "기온이 높아지는 여름철에는 세균성 식중독이 많이 발생할 수 있다"면서 "모든 급식시설에서 채소류는 충분히 세척하고 육류는 내부까지 완전히 익혀 제공하는 등 각별한 주의를 기울여 달라"고 당부했다.
KPI뉴스 / 권라영 기자 ryk@kpinews.kr
[저작권자ⓒ KPI뉴스. 무단전재-재배포 금지]
























